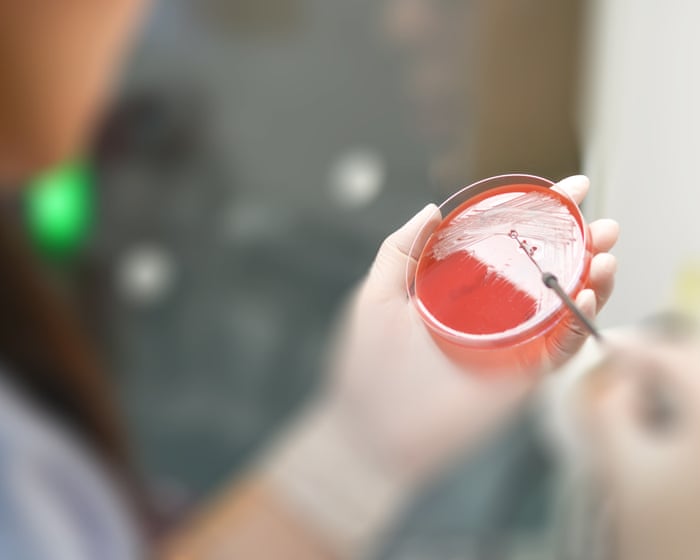

‘As new infections outpace new drugs, are we sleepwalking into a global health disaster?’ | Dr Manica Balasegaram
NegativeWorld Affairs
A new report highlights the alarming rise of antimicrobial resistance, warning that the world is at risk of a health disaster as new infections outpace the development of new drugs. Despite previous political momentum, the urgency to address this crisis has waned, raising concerns about our preparedness for a potential calamity. This issue is critical as it parallels the climate crisis, emphasizing the need for immediate action to safeguard public health.
— Curated by the World Pulse Now AI Editorial System






